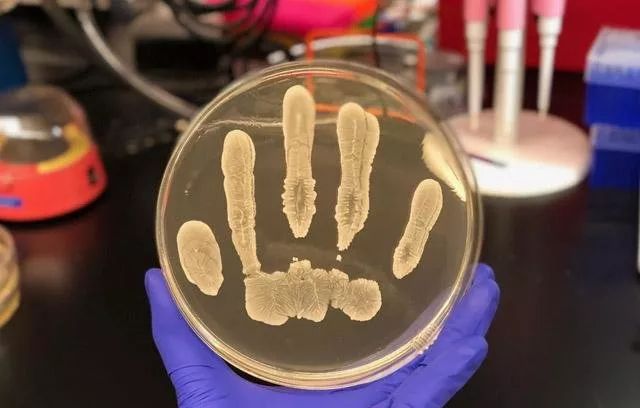

“细胞图谱”首份成绩单、中国造创新HIV疗法获批…… | 一周事
本周回顾,2018中国最好大学排名出炉,清华、北大、浙大位列前三;FDA批准10年来首款创新HIV疗法;“人类细胞图谱计划”首份成绩单,完成25万发育细胞测序工作;大牛David Liu最新Nature:“升级版”Cas9,让基因编辑更灵活精确;糖尿病是5种不同的疾病;PNAS:牵手真能减轻女性痛感……更多资讯,请跟随小编一起回顾吧。
产业动态
12018中国最好大学排名出炉,清华、北大、浙大位列前三!
2018年2月26日,软科正式发布2018“中国最好大学排名”。排名展示了中国综合实力最强的600所大学,清华大学、北京大学、浙江大学位列前三,上海交通大学、复旦大学、中国科学技术大学、南京大学、华中科技大学、中山大学、哈尔滨工业大学依次排在4到10名。
2中国造!FDA今日批准10年来首款创新HIV疗法
3月7日,美国FDA宣布批准中裕新药(TaiMed Biologics)的Trogarzo(ibalizumab-uiyk)上市,作为一种全新的抗逆转录病毒疗法,治疗现有多种疗法均无法起效的成人HIV感染者。值得一提的是,这是美国FDA在2018年批准的首款创新生物药。
3首个!FDA批准直接面向消费者的BRCA基因癌症风险检测产品
当地时间3月6日, 美国FDA批准了个人基因检测公司23andMe的癌症风险基因检测报告,用于检测三种BRCA1和BRCA2基因突变。这些基因与女性乳腺癌和卵巢癌的风险显著升高,男性前列腺癌的风险显著增加有关。值得注意的是,这也是FDA批准的首个直接面向消费者的BRCA基因癌症风险检测产品。
4福布斯2018中国最杰出商业女性,8名医药高管上榜!
福布斯日前发布“2018中国最杰出商界女性TOP100排行榜”,这也是福布斯第四次发布这个中国本地商界女精英榜单,其中,拜耳大中华区总裁朱丽仙、强生中国总裁谢冰等医药企业掌门人在列。
5共话行业发展!2018EBC易贸生物产业大会第一现场
2018易贸生物产业大会(EBC)于3月8日上午在苏州正式开幕,超1000位行业精英参与了这场盛会。本次会议由易贸医疗主办,诸多行业协会、机构、企业支持协办,大会聚焦精准医疗,覆盖诊断、治疗、用药全产业链,融合政策导向、市场投资、技术研发、临床应用等话题。
6建议改为备案制!提高人类遗传资源行政审批效能 | 2018政协提案
两会在北京召开的如火如荼,国内的几位著名的肿瘤专家也作为全国的委员参加了会议。秦叔逵教授, 季加孚教授, 王水教授, 吴德沛教授等提出关于提高人类遗传资源行政审批效能,提升我国医药创新竞争力的建议。
72018全国两会 | 医药界代表都说了什么?
十三届全国人大一次会议、全国政协十三届一次会议将分别于2018年3月5日和3月3日在北京开幕,两会代表、委员名单也已经全部出炉。今年有70多位医药界人士将为医药行业的改革和发展建言献策。这实际与国家鼓励药物创新的政策密切相关。
研究动态
1“人类细胞图谱计划”首份成绩单!25万发育细胞测序完成
2017年10月16日, “人类细胞图谱计划” 正式公布了首批拟资助的38个项目,拉开了其绘制人体40万亿细胞“蓝图”的大愿景。4个多月后的今天,该计划收获了第一份“果实”——来自于Wellcome Sanger研究所和纽卡斯尔大学的研究团队解析了25万个发育细胞的图谱,让世界惊喜!
2CAR-T疗法突破成果“接踵而至”!先后登Science和Nature子刊
近日,CAR-T疗法连续取得突破性成果!先是,来自美国和意大利的科学家团队为CAR-T对抗一种致命脑瘤找到了更好的靶点;紧接着,来自日本的研究小组开发了一种升级版的CAR-T疗法,可使得小鼠实体瘤完全消除。
3大牛David Liu最新Nature:“升级版”Cas9,让基因编辑更灵活精确
近期,就在张锋、Jennifer Doudna争先发表最新成果的同时,同样在CRISPR领域有“大神”之称的David R. Liu教授也在Nature期刊发表了一项突破性成果。他带领团队获得了一种“升级版”的Cas9酶,并证实可以编辑更多的基因位点。
4NEJM:一种新药可治17种癌症,有效率为75%
近日,研究人员对一款名为拉罗替尼(larotrectinib)的药物研究结果显示,该药对于年龄为4个月至76岁的患有17种不同癌症患者诊断的总体应答率为75%。
5最新研究证实!糖尿病是5种不同的疾病 |《柳叶刀》子刊
据英国BBC报道,一项最新研究证实,糖尿病实际上是五种不同的疾病。领导这项研究的科学家们认为,他们所发现的这种更复杂的分类,将引领糖尿病治疗迈向个性化医疗时代。
6“疼的话就握着我的手” | PNAS:牵手真能减轻女性痛感
“疼的话就握着我的手”——在许多影视剧中,经常会看到这样的话语。现在,最新一项研究证实,这种做法除了暖心,真的有效:科学家们发现,当握着爱人的手,可以减轻女性一半的疼痛感。
7Science重大成果:我们的寿命多大程度由基因决定?只有16%!
我们的寿命多大程度是由基因决定的?相信很多人都对这个话题感兴趣。最近,科学家们给出了一个新的估计:答案是,只有16%。最新刊登在Science上的一项研究发表了可能是有史以来最大的家谱:这一里程碑式的数据集关联了有血缘或婚姻关系的1300万人,平均跨越11代。
8新作用!Science子刊:这种细菌可以预防皮肤癌
近日,发表在《Science Advances》杂志上的一项研究中,加州大学圣地亚哥分校医学院的研究人员表示,皮肤上的一些细菌有预防癌症的新作用。
9基因疗法又下一城!治疗遗传性失明,两年内开始人体试验
近两年来,基因疗法可谓是风头无二。随着第一个基因疗法得到了FDA的批准, 目前有超过2500个基因疗法正在进行临床试验,包括120多个关键的2/3期或3期临床研究。近期,宾夕法尼亚大学传来消息,基因疗法“又下一城”,对于治疗遗传性失明(卵黄状黄斑变性)有较好效果,科学家预计相关人体试验将在2年内进行。
10Science:神经系统可以对炎症 “踩刹车”
根据威尔康奈尔医学院科学家的最新研究,神经系统中的细胞可以“抑制”肠道和肺部感染的免疫反应,以避免过度炎症。这一观点或许可以为哮喘和炎症性肠病带来新的治疗方法。研究结果发表在3月1日《Science》杂志上。
11这一次基因又“输”了!Nature:环境是塑造肠道菌群的主因
前几日,《Science》期刊上发表一篇文章揭示,基因对于寿命的决定程度预估只占16%。这意味着,环境对于寿命的影响高于我们的预期。现在,《Nature》期刊再出一篇重磅:对于人类肠道微生物的组成,环境的作用同样远远大于基因!
12第三种基因标记!Science:对抗HIV新突破
尽管有些人天生就比其他人更容易感染人类免疫缺陷病毒(HIV),但迄今为止只有两种明确的基因解释。近日,研究人员又发现了第三个基因标记,它能够更好的控制非洲后裔的HIV病毒,或为新的治疗策略提供线索。
13最新证据!高水平维生素D或能降低患癌风险
最新发表在BMJ上的一篇论文证实,一项针对日本成年人的大型研究发现,高水平的维生素D可能与患癌(包括肝癌)风险降低有关。
End
本文系生物探索原创,欢迎个人转发分享。其他任何媒体、网站如需转载,须在正文前注明来源生物探索。